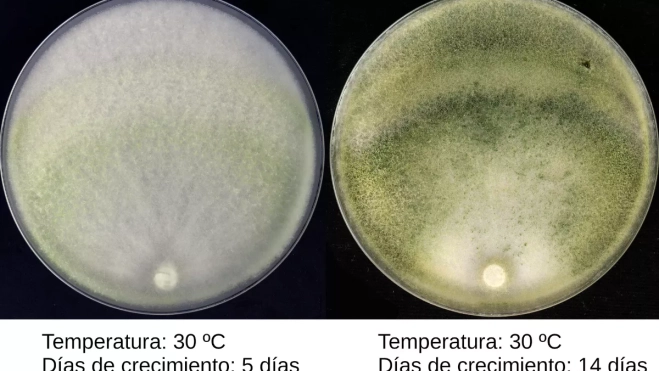
Crecimiento en laboratorio de la nueva especie de hongo 'Trichoderma ichasaguae' / CEDIDA

Un equipo de investigadores del Instituto Canario de Investigaciones Agrarias (ICIA) ha descubierto una nueva especie de hongo en suelos de cultivo de platanera del municipio de Adeje, en el sur de Tenerife, a la que han dado el nombre de Trichoderma ichasaguae.
Esta especie era hasta ahora completamente desconocida por la ciencia. Aunque invisible a simple vista, forma parte de los millones de microorganismos que viven en el suelo agrícola y que ayudan a mantener la salud de los cultivos, como es el caso de la enfermedad “mal de Panamá”, causado por el patógeno Fusarium oxysporum, que afecta a las plataneras.
Muestras de suelo de plataneras
Según recoge la investigación, llevada a cabo por los científicos Raquel Correa-Delgado y Federico Laich y que ha sido publicada en la revista científica internacional Current Microbiology, el hongo fue encontrado en muestras de suelo tomadas alrededor de las raíces de plantas de platanera en una finca del sur de Tenerife, en Adeje.
Para confirmar que se trataba de una especie nueva, los científicos recogieron muestras en campo, aislaron los hongos en laboratorio y analizaron su ADN para compararlo con el de otras especies ya conocidas del género Trichoderma.
Una especie nunca descrita
Los resultados mostraron que este microorganismo constituye una línea evolutiva distinta dentro de este grupo de hongos, compuesto por más de 400 especies, conocido por su presencia en suelos de todo el mundo y por su papel ecológico en el suelo.
Con la confirmación de que se trata de una especie nunca descrita hasta ahora, los investigadores han decidido ponerle el nombre ichasaguae para rendir homenaje a Ichasagua, una figura histórica guanche vinculada al territorio de Adeje. De esta forma, se establece un puente simbólico entre la biodiversidad actual del archipiélago y su memoria histórica.
Ayudan contra las enfermedades
A pesar de ser invisible a simple vista, este hongo forma parte de la compleja comunidad de microorganismos que habitan en el suelo y que contribuyen al funcionamiento de los ecosistemas agrícolas.
Muchas especies del género Trichoderma son conocidas por su capacidad para favorecer el crecimiento de las plantas y actuar como agentes de control biológico frente a patógenos agrícolas, es decir, ayudan a proteger los cultivos frente a enfermedades.
En el caso de la platanera, uno de los cultivos más importantes de Canarias, estos microorganismos pueden desempeñar un papel clave en la lucha contra enfermedades como el llamado “mal de Panamá”, causado por el patógeno Fusarium oxysporum.
Futuros estudios
Aunque aún es necesario investigar en detalle las propiedades de Trichoderma ichasaguae, los científicos señalan que su descubrimiento abre la puerta a futuros estudios sobre su posible uso en estrategias de agricultura sostenible y esperan ampliar la investigación a otras islas con el objetivo de conocer toda su diversidad.
Para los investigadores el hallazgo refuerza la idea de que los suelos agrícolas de Canarias esconden una gran diversidad de vida microscópica que aún está por conocer, además de lo esencial que son estos ecosistemas vivos para la productividad agrícola, la sostenibilidad y la resiliencia frente al cambio climático. “Conocer y conservar esta biodiversidad invisible es un paso fundamental para avanzar hacia modelos agrícolas más respetuosos con el medio ambiente”, concluyen.